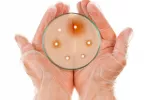
Resistencias a antibióticos Resistencias a antibióticos en una placa de petri

Qué son los antibióticos: clasificación

Los antibióticos son medicamentos con la capacidad de destruir un organismo patógeno vivo, o de inhibir su desarrollo.
Actualizado: 21 de septiembre de 2022
Los antibióticos son medicamentos seguros y de gran eficacia que, desde que se produjo el descubrimiento de la penicilina en 1928 y su posterior comercialización en los años 40, han constituido la medida terapéutica que ha obtenido mayor éxito en la disminución de los porcentajes de mortalidad. Sin embargo, no siempre los usamos como es debido, ya que su uso está indicado para prevenir y tratar enfermedades producidas por bacterias, y no resultan efectivos ni se deben emplear en el tratamiento de patologías que, como la gripe, son causadas por virus.
Para saber cuándo recurrir a ellos, en primer lugar debemos saber que un antibiótico es una sustancia capaz de destruir un organismo vivo, o de impedir su desarrollo. Su origen puede ser diverso, pues pueden proceder de:
Clasificación de los antibióticos
Dependiendo de su acción, los antibióticos se clasifican como:
Otra clasificación se basa en su mecanismo de acción. Si actúan inhibiendo el crecimiento de gérmenes nocivos, se denominan bacteriostáticos y, si los destruyen, bactericidas.

Antibióticos bactericidas:
Antibióticos bacteriostáticos:
Creado: 16 de agosto de 2010